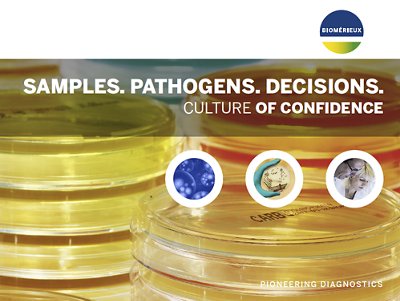
Samples. Pathogens. Decisions. Culture of Confidence.

What are Fungal Infections and How Does Resistance Impact Treatment?
Fungal infections are becoming increasingly common and fungi’s growing resistance to antifungal treatments poses a serious threat to public health. With only four classes of antifungal medicines currently available and just a few new candidates in the clinical pipeline, it is imperative that healthcare facilities prescribe antifungal drugs appropriately, test for fungi resistance in patients who are not improving and are aware of resistance in their facilities and communities.1
The invasive forms of fungal infections often affect severely ill patients and those with significant underlying immune system related conditions. Populations at greatest risk of invasive fungal infections include those with cancer, HIV/AIDS, organ transplants, chronic respiratory disease, and post-primary tuberculosis infection.2 While the most common pathogenic yeast species is Candida albicans, it is important to consider other species including Candida auris – which the World Health Organization (WHO) has identified as a fungal pathogen of critical priority.
One factor that is threatening to make several infection-causing fungi more widespread is climate change. Climate change can increase the geographic range of pathogenic species or their vectors, leading to the emergence of diseases in areas where they have not previously been reported.3
The rise of Candida auris is alarming as it is a yeast that is often-multidrug resistant and can cause invasive infections and outbreaks in healthcare facilities that are difficult to mitigate.4
Our Solution for Diagnosing Fungal Infections
Early diagnosis of fungal infections and the implementation of appropriate treatment contribute greatly to improved outcomes for patients. Every minute counts to identify patients at high risk of a life-threatening condition. It is important to rapidly identify Candida infections in positive blood culture, alongside other potential pathogens using a syndromic approach. Septic patients with polymicrobial and fungal infections are extremely critical and often have the highest mortality rate compared to other types of bloodstream infections. It is also important to consider that prosthetic and native joints can be impacted by fungal infections.5
Solutions Overview
- Fungi Identification: Our CHROMID® Candida Media is designed for Candida species detection and is unique with direct identification of the most prevalent Candida albicans pathogen within 24-hours. It means faster time to results for patients in critical care. CHROMID® Candida Media allows the detection of all Candida pathogens including Candida auris.
- Bloodstream Infections: The BIOFIRE® BCID2 Panel can identify seven fungal infection pathogens, alongside 26 other organisms commonly found in bloodstream infections and 10 associated AMR genes. The BIOFIRE® BCID2 Panel has minimal hands-on time, with results in about an hour, helping microbiologists and clinicians quickly identify the causative pathogen in positive blood cultures from patients with suspected fungal infections.
- Joint Infections: Conventional testing for joint infections is complex, often requiring multiple patient samples, various send-out tests, and days of waiting for results. The BIOFIRE® Joint Infection Panel is a rapid syndromic test that delivers comprehensive results in about ~1 hour. With 2 fungal, 29 Bacterial, and 8 AMR targets, the BIOFIRE® JI Panel can facilitate improved management of fungal and polymicrobial detections.
- Meningitis/Encephalitis: Traditional testing for meningitis and encephalitis requires multiple patient samples and can take days to receive results. The BIOFIRE® FILMARRAY® Meningitis/Encephalitis Panel offers fast results in about ~1 hour from just a 0.2 mL CSF sample. It detects 14 common bacterial, viral, and fungal pathogens, helping healthcare providers to quickly identify the causative pathogen for this time sensitive diagnosis.
Fungal Infections – Our Diagnostic Offer
We offer flexible options for identification of fungal infection pathogens. Additionally, integration of bioMérieux solutions can help to maximize efficiency in the laboratory with innovative automation and efficient use of IT solutions that will ensure the right information is in the right hands as quickly as possible.
Disclaimer: Product availability varies by country. Please consult your local bioMérieux representative for product availability in your country.
-
Chromogenic & High Medical Value Media
Patented chromogenic media for rapid, reliable culture & identification
The innovative and extensive CHROMID® range of chromogenic media is the easy way to rapidly and reliably detect and identify microorganisms for faster/direct ID of pathogens and MDRO. The intensity and specificity of the colors of CHROMID® make identification and results clear to see, even with mixed cultures .
-
BIOFIRE® Blood Culture Identification 2 Panel
1 Test. 43 Targets. ~1 Hour.
The BIOFIRE BCID2 Panel tests for 43 targets associated with bloodstream infections, including Gram-negative bacteria, Gram-positive bacteria, yeast, and 10 antimicrobial resistance genes – all with one test and with results available in about an hour from positive blood culture.
-
BIOFIRE® Joint Infection (JI) Panel
1 Test. 39 Targets. ~1 Hour.
Using PCR technology, the BIOFIRE JI Panel is a rapid syndromic test that delivers comprehensive results in one easy-to-read report.
-
BIOFIRE® FILMARRAY® Meningitis/Encephalitis Panel
1 Test. 14 Targets. ~1 Hour.
The BIOFIRE ME Panel provides answers on 14 of the most common bacterial, viral, and yeast pathogens that cause central nervous system infections to help healthcare providers rapidly distinguish between bacterial and viral meningitis and optimize life-saving therapy.
-
VITEK® MS PRIME
New-Generation Mass Spectrometry Microbial Identification System
VITEK® MS PRIME combines microbiology expertise with innovation taking mass spectrometry to the next level by maximizing the impact of daily laboratory workflow for better patient care.
Useful Resources for Fungal Infection Diagnostics
References
1. Antimicrobial-Resistant Fungi | Fungal Diseases | CDC. (2022, September 30). Www.cdc.gov. https://www.cdc.gov/fungal/antifungal-resistance.html#tackling
2. WHO releases first-ever list of health-threatening fungi. (2022, October 25). Www.who.int. https://www.who.int/news/item/25-10-2022-who-releases-first-ever-list-of-health-threatening-fungi
3. Nnadi, N. E., & Carter, D. A. (2021). Climate change and the emergence of fungal pathogens. PLOS Pathogens, 17(4), e1009503. https://doi.org/10.1371/journal.ppat.1009503
4. Ahmad, S., & Alfouzan, W. (2021). Candida auris: Epidemiology, Diagnosis, Pathogenesis, Antifungal Susceptibility, and Infection Control Measures to Combat the Spread of Infections in Healthcare Facilities. Microorganisms, 9(4), 807. https://doi.org/10.3390/microorganisms9040807
5. Mishra, A., & Juneja, D. (2023). Fungal arthritis: A challenging clinical entity. World Journal of Orthopedics, 14(2), 55–63. https://doi.org/10.5312/wjo.v14.i2.55